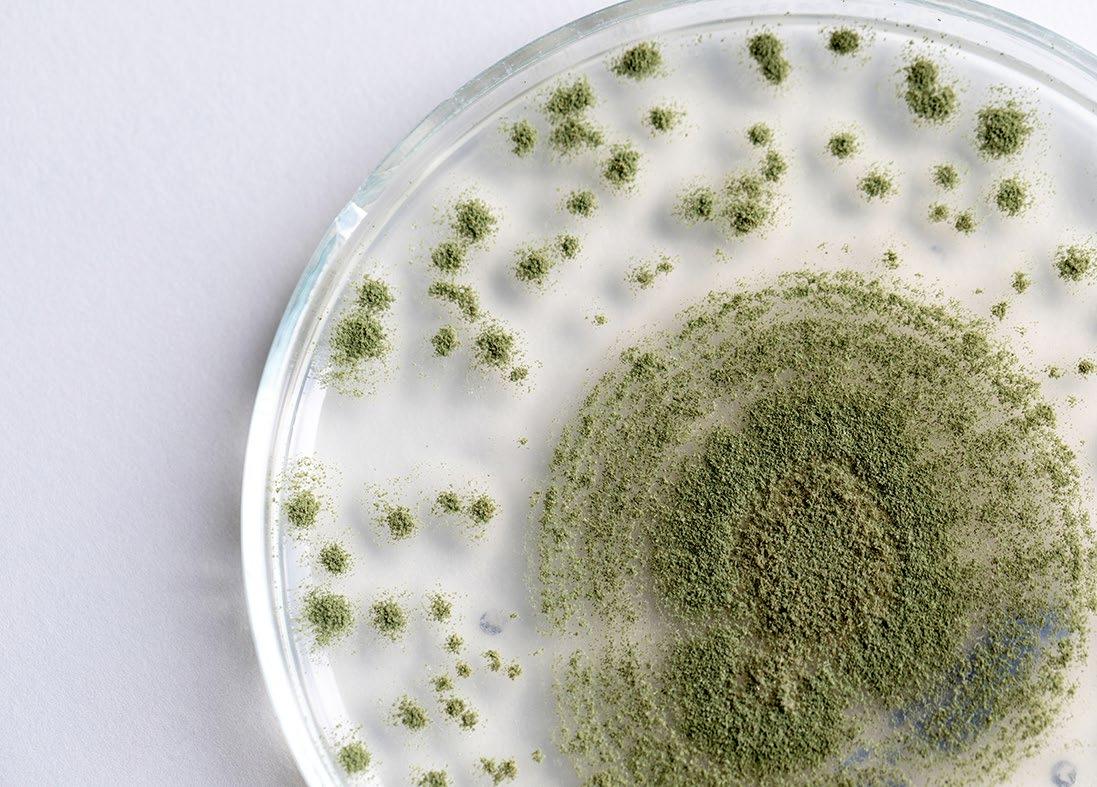

Biomarkers of MYCOTOXINS EXPOSURE in swine


Associate



Associate
Various mycotoxins can be detected in grains used as pig feedstuffs worldwide and their concurrent presence has been widely reported.
Research efforts over half a century have proven that mycotoxins can pose a significant threat to health, performance, and reproductive efficiency of swine. They are secondary metabolites of certain fungi (genera Aspergillus, Penicillium, Fusarium, Alternaria, and Claviceps)[1] and are produced before harvest of grains (fungi as plant pathogens), or during storage (fungi growing saprophytically).
Some are considered extremely significant for pig health and performance. Namely, aflatoxins (Afs: B1, B2, G1 and G2, deoxynivalenol (DON), zearalenone (ZEN), fumonisins (FBs: FB1, FB2, FB3) and ochratoxin A (OTA) are considered significant for their devastating effects on pig production worldwide.


Other mycotoxins such as T-2, nivalenol, or ergot alkaloids have been suggested as somewhat significant for swine, especially in particular geographical regions[2,3]
Data at a global scale showed that up to 80% of feed and food crops are contaminated with mycotoxins, and that co-contamination of grains with more than one mycotoxin is common[4-6]

According to the European Commission[7,8], the maximum contamination levels in swine feed should not exceed 0.02 mg AFs/kg feed, 0.9 mg DON/kg feed, 5 mg FBs/kg feed, 0.05 μg OTA/kg feed, 0.1 mg ZEN/kg feed for piglets and gilts and 0.25 mg ZEN/kg feed for sows and fattening pigs, respectively.
The term “biomarker”, which equals “biological marker”, refers to a broad subcategory of objective indications of a medical state that can be measured accurately and reproducibly[9,10]
Therefore, as regards mycotoxins exposure, the predominant characteristic of a biomarker is its accurate and reproducible measurement in biological matrices which could provide information on the total level of exposure to mycotoxins.
Assessment of particular biomarkers provides information on individual exposure, whereas it could assist in the explanation of biological consequences of mycotoxins in animals, observed as toxic effects[11]

Such an approach is increasingly used in monitoring human exposure to mycotoxins[12,13] , which is reported as human biomonitoring (HBM), whereas a quite similar animal biomonitoring (ABM) process could be also successful in assessing animal exposure[14]
Nevertheless, it is true that feed analysis for the presence of mycotoxins has a number of disadvantages when compared to biomonitoring as a diagnostic tool for mycotoxicosis cases. These include facts that may affect the validity of feed analysis results in comparison to the true mycotoxin contamination levels.
Such facts are the uneven distribution of mycotoxins in feed, the risk of improper sampling procedures, the absence of testing of modified or conjugated forms in feed which can convert back to the parent forms and hence contribute to their adverse effects, as well as the lack of information on individual animal exposure from the feed analysis results.

However, a critical point as regards diagnosis of mycotoxin cases in pigs under field conditions, is that clinical signs of mycotoxin exposure can appear when the contaminated feed has already been consumed.

Thus, diagnosis in such cases becomes complicated or even impossible[15]. That is one of the significant advantages of biomonitoring when compared to the classical feed analysis approach[16]
On the other hand, analytical methodology is largely lacking multi-mycotoxin methods for pig excreta and only a limited availability is found for pig urine or other matrices, while as already reported the exposure to a mixture of mycotoxins through feed in pigs is widely observed[6,15]
Therefore, it seems that the use of biomarkers in mycotoxicosis cases could become a significant key for early understanding exposure levels and for the diagnosis of mycotoxicosis in swine.
The present review wishes to highlight the major biomarkers which could be evaluated in swine mycotoxicosis cases and address possible future prospects.

Differences in metabolic properties and toxicokinetics of each mycotoxin play a significant role in selecting specific biomarkers, whereas their interactions when present together in contaminated feed, have not been fully investigated.
In order to discuss possible utilisation of biomarkers of exposure of the most important mycotoxins for pigs, major aspects of their metabolic and toxicokinetic properties are presented.


AFs are produced mainly by Aspergillus flavus, A. parasiticus and A. nomius and are detected usually in maize, peanuts and cottonseed.
The most common AFs are B1, B2, G1 and G2.
AFB1 is the most significant in terms of toxicity in swine[17]. AFs apart from hepatotoxicity, they have mutagenic, and possibly teratogenic properties in animals.
As regards pigs, 20-50 % of the administered dose of AFB1 is excreted as AFB1 and AFM1 via urine. The amount of AFM1 is 20% of the total excreted dose[18]. Previously Luthy et al.[19] had also detected 20% of the administered dose in pig urine and 50-62% in pig faeces.
AFs and, in particular, AFB1 are considered the most potent naturally occurring carcinogens. AFB1 is metabolised predominantly in the liver by a number of cytochrome P450 enzymes, generating several hydroxy-metabolites, such as AFM1, AFQ1 and AFP1 and two significantly reactive epoxides, AFB1 exo8,9-epoxide and AFB1 endo-8,9-epoxide[20-22]
The exo-epoxide interacts with the guanine part of DNA, resulting in the formation of AFB0-guanine adducts such as AF-N7-Gua which can be used (in urine) as a biomarker of exposure[20,21,23]

Both the endo- and exo-epoxide of AFB1 are toxic and lead to the formation of aflatoxin–albumin (AF-alb) in hepatocytes, which are observable in the sera of exposed animals and humans[20]. These albumin adducts of AFs have been discussed as useful biomarkers of AFs-induced hepatotoxicity[20]

On the other hand, DON as a member of the trichothecene B group, is produced by Fusarium fungi which are one of the most important phytopathogenic fungal genera groups. That group is also responsible for the production of ZEN and FBs[15]
DON’s main mode of action includes the inhibition of protein synthesis by interference with the termination step of the polypeptide chain, which is a part of the elongation step of the protein synthesis that is carried out in the 60S ribosomal unit.
Acute DON intoxications in pigs are clinically observed as signs of abdominal pain, increased salivation, diarrhoea and emesis (3.6-40 mg DON/kg feed) [24], whereas lower DON contamination levels result in reduced feed intake and decreased weight gain, growth retardation, immuno-toxicity, impaired reproduction and development[25]
DON is rapidly (maximal plasma concentration after 15-30 min. of exposure) absorbed in pigs (approximately 90% of ingested dose). DON is distributed to all tissues and can undergo different detoxification pathways, including mainly microbial degradation in the gastro-intestinal tract and secondly a biotransformation in tissues such as the liver[15,26,27]

DON can be metabolised by intestinal microbes to de-epoxy-DON (DOM-1) that can be found in plasma or excreta[28]. In pigs, microbial formation of DOM-1 mainly occurs in the distal part of the digestive system, whereas DON is predominantly absorbed in the upper digestive tract, thus partially “avoiding” microbial de-epoxidation[28,29] DON and DOM1 can be conjugated with glucuronic acid and sulphate while in pigs glucuronidation is more common[30]

The development of an exposure biomarker for DON by quantifying urinary free-DON and a DON-glucuronide combined as total urinary DON was suggested by observations in a rodent model[31]
As regards pigs and the possible use of total urinary DON as a potential biomarker of exposure, it should be highlighted that the major excretion pathway for DON is indeed through urine, according to Prelusky et al.[32] who reported that 54–85% of radioactive labelled DON administered intra-gastrically to pigs was excreted in urine within 24 hours.
It has been reported that about 40–60% of DON in urine is glucuronide conjugated[18,33], whereas the amount of DOM-1 in urine is approximately 2—5% of the DON in urine, and 1–5% of the DON intake[34-37]. A linear increase in urine concentration of DON with increasing dietary DON concentration has been demonstrated[36]. On the other hand, the amount of DON that reaches the faeces is negligible and includes 0.1 - 5% of the intake[15]
The fumonisins are a family of toxins produced mainly by Fusarium verticillioides and F. proliferatum, with FB1 and FB2 as the most frequently observed, whereas FB1 represents approximately 70% of the natural contamination of maize[38]
In contrast to other Fusarium mycotoxins, FB1 is poorly absorbed from the gastro-intestinal tract of pigs with an oral bioavailability of approximately 4% of the administered dose[39,40]
Distribution to tissues has been found predominantly in the liver and kidney, besides the large intestine and brain and to a smaller extent lung, heart and adrenal gland.
FB1 also undergoes enterohepatic circulation, which extends its biological elimination half-life. Its metabolism takes place by microorganisms in
the small intestine and results in the formation of fully hydrolysed FB or aminophenol (AP) and partially hydrolysed FB1 (PHFB1).
FB1 is mainly excreted via faeces of pigs (>90%) with maximum concentration at 48h after administration and to a lesser extent via urine (± 5%) as FB1[15]

FB1 has a sphingoid backbone and can inhibit ceramide synthase, resulting in the modulation of two physiologically important precursors in sphingolipid production: sphinganine (Sa) and sphingosine (So), thus inducing accumulation of sphinganine (Sa) and sphingosine (So) in tissues, serum and urine[41] and an increase in the Sa/So ratio.
That mechanism has been recognized as the causal pathway for FBs toxicity. This leads to reduced nutrient absorption, anorexia, decreased daily weight gain and hepatotoxicity in pigs[15]
Signs of encephalopathy and cardiac dysfunction with pulmonary oedema have been observed after administration of FB1[42]
According to EFSA recommendations (Table 1) sphinganine/sphingosine ratio in blood should be held as the gold standard of FBs biomarkers in swine.
Aspergillus species mainly, and Penicillium species can produce ochratoxins with OTA having major nephrotoxic properties.
OTA is passively and rapidly absorbed from the stomach and the proximal duodenum after oral ingestion. Approximately 66% of oral administered OTA is absorbed in pigs[15,43,44]
OTA in the systemic circulation has a high affinity for plasma proteins, especially to albumin, therefore 99% of the absorbed fraction will be bound to plasma proteins in pigs (<0.2% OTA free fraction in serum).


Thus, the absorption of OTA from the gastrointestinal tract is stimulated resulting in prolongation of its presence in the body, slowing both its biotransformation and excretion half-life[15,45]
OTA can be metabolised in the kidney, liver and intestines whereas major metabolic pathways include hydrolysis, hydroxylation, lactone-opening and conjugation.
OTA can undergo phase II metabolism with the formation of glucuronic acid and sulphate conjugates, whereas only the glucuronic acid conjugates have been detected in the bile of pigs[15]
The metabolite OTalpha (OTα) is formed by the cleavage of the peptide bond in OTA and is considered as a nontoxic product[46]

OTA largely remains unchanged after ingestion in pigs and can accumulate in the meat and organs due to high bioavailability, limited conversion rate into OTalpha and long half-life.
OTA is excreted via urine (via tubular secretion) and faeces (via biliary excretion). However, the occurrence of OTA reabsorption all nephron segments has been reported, resulting in retarded excretion and accumulation of OTA in the kidney, where it exerts its main toxicity

ZEN is a macrocyclic β-resorcylic acid lactone with structural similarity to naturally occurring oestrogens, thus reproductive disorders in swine have been predominantly linked to ZEN toxicity, following the binding of ZEN to oestrogen receptors.
Hyperestrogenism in pigs observed at doses of 0.06 and 0.15 mg/kg feed includes signs of reddening, hyperaemia and oedematous swelling of the vulva, enlargement of the uterus with cyst formation on the ovarian and enlargement of the mammary glands, whereas vaginal or rectal prolapse in such cases has been also reported.
Gilts are significantly sensitive to the toxic effects of ZEN since their concentrations of 17β-oestradiol are lower compared to sows.
On the other hand, signs in boars include atrophy of the testes, reduction of the concentration of spermatozoa and oedematous swelling of the preputium and mammarian complex. Moreover, embryotoxic and teratogenic properties of ZEN have been described[15,48].
ZEN is rapidly absorbed after oral exposure with an oral bioavailability of approximately 80% of the administered dose in pigs[48]
ZEN is metabolised via phase I and II reactions. ZEN metabolism in pigs includes a phase I reduction of ZEN, by the microbial organisms in the gastrointestinal tract of pigs and by 3α or 3β-hydroxysteroid dehydrogenases in the liver, oocytes and intestinal mucosa, to predominantly α-zearalenol (α-ZEL) and at a lower level to β-zearalenol (β-ZEL)[15, 49], while also α-zearalanol (α- ZAL), β-zearalanol (b-ZAL) and zearalanone (ZAN) can be formed.
The α-ZEL is considered a bioactivation product as a more potent metabolite[2,49]. ZEN and its phase I metabolites can undergo phase II conjugation with glucuronic acid and sulphate (through catalysis by by uridine 5'-diphospho-glucuronosyltransferases and sulfotransferases) [48]. Both glucuronidation and sulfation are considered as detoxification pathways[15]
As regards ZEN possible biomarkers of exposure, Olsen et al.[50] reported that 15.6% of ingested ZEN from 5 mg/kg feed was excreted in urine as ZEN (mostly as glucuronide conjugates) and α-ZEL within 8 h.
Similarly, Zöllner et al.[51], estimated that approximately 14% of ZEN intake was excreted in urine either as parent toxin or as metabolites within 8 h.
However, Dänicke et al.[53] reported 30% urine excretion of ZEN within 6 h after female pigs had been given a single bolus of 1 mg ZEN/kg body weight, whereas up to 70.4 % of the dose was excreted in urine within 72 h.
Taken together, 40% of the administered dose of ZEN can be recovered in urine (26±10%) and faeces (14± 3%) in pigs, as ZEN or its metabolites at 48h after administration[15]

Faecal samples have been shown to contain ZEN and α-ZEL, which are also present in plasma, whereas in urine ZEN and ZEN-GlcA are detected[51,52]
As previously suggested biomarkers are defined as substances measured in biological systems linked to effect, exposure or susceptibility[53] , while the measurement of these markers in biological matrices is known as biomonitoring
Biomonitoring has two major applications which include exposure assessment and in vivo efficacy testing of candidate mycotoxin detoxifiers[15]
Biomarkers can be categorised based on their characteristics and use as follows[15,54]:
Biomarkers of exposure: They provide evidence of exposure of individuals to xenobiotics (such as mycotoxins) through an estimation of the concentrations of these compounds or their metabolites in biological matrices. They are often the mycotoxin itself or/and its phase I and II metabolites or interaction products.
Biomarkers of effect: They are connected with the measurement of biochemical, physiological, or behavioural alterations in the organism which can be attributed to a possible or established health effect.
Biomarkers of susceptibility: They are used as indicators of an ability (inherent or acquired) to respond to exposure to xenobiotics.
Based on the above-mentioned differences among species and metabolic/toxicokinetic properties of various mycotoxins, the European Food Safety Authority (EFSA)[55] has recommended endpoints/ biomarkers (Table 1) as proper validation endpoints of the efficacy of a feed additive which claims adsorbing or modifying capability against mycotoxins.
The selection of the appropriate endpoint should be based on the mycotoxin and target species, whereas the availability of sensitive analytical methods validated for the specific matrices should be taken into account.

However, it has been suggested that the abovementioned biomarkers may not always be the most optimal for each mycotoxin[15]
DON concentrations in blood serum could be a relevant biomarker for exposure, but on the other hand, DON undergoes an extensive phase II biotransformation to DON-GlcA in pigs, therefore, that metabolite could be considered as more precise biomarker for exposure than DON itself[30]
Furthermore, even though biomarkers for exposure have been defined for particular mycotoxins in some animal species, the identification of the suitable biomarker for each mycotoxin in a certain species and specific biological matrix is often missing[15]
Table 1. Recommended relevant endpoints/biomarkers for substances claiming ability to reduce contamination of feed by mycotoxins[55]
Aflatoxin B1 Aflatoxin M1 in milk/egg yolk.
Fumonisins B1 + B2 Sphinganine/sphingosine ratio in blood, plasma or tissues.
Ochratoxin A Ochratoxin in kidney (or blood serum).
Zearalenone Zearalenone + a- and b-zearalenol in plasma. Excretion of zearalenone/metabolites.
Deoxynivalenol DON/metabolites in blood serum.
The most widely used biological matrices are urine and blood, whereas biomarkers can be also detected, in hair, saliva and faeces.
Urine, plasma and faeces can be collected easily in living pigs, whereas bile or organs can be also useful matrices, but they are collected post-mortem. Thus, biomonitoring on easily accessible matrices, which can be collected through non-invasive and non-stressogenic processes, is gaining more interest in recent years.
Dried blood spots (DBS), hair and saliva are among such matrices, which have reduced storage and transport requirements. Until today methods are available for mycotoxins in DBS and hair of animals and humans, whereas for the detection in saliva they are not fully available[15]
Assessment of DBS for multi-mycotoxin biomarker analysis in pigs has been previously reported[56]. In that study, a method was developed and validated for the determination of 23 mycotoxins and their phase I and II metabolites in DBS of pigs, whereas under in vivo exposure conditions, a strong correlation was observed between plasma and DBS concentrations. Findings supported DBS as an interesting micro-sampling technique for use as a non-invasive biomonitoring system of mycotoxins exposure in swine.

Findings through transcriptomics approaches indicated that ZEN can induce dose-dependent alterations of several uterine MiRNAs, whereas such effect was partly reflected in serum of exposed animals, thus providing evidence for a novel mycotoxin biomarker discovery[57]
Evaluation of DON-induced changes in the MiRNAs expression in porcine liver, jejunum and serum, proved a time dependent serum MiRNAs response to DON which declined after removal of contaminated diets.
Moreover, recent findings suggested that circulating microRNAs (MiRNAs: small non-coding RNAs) have remarkable potential to serve as indicators for pathological processes in tissues, such as the case of toxic effects induced by ZEN[57] and DON[58], OTA and AFB1[59]
MiRNAs can be viewed as characteristic biomarkers whose levels can be directly measured in serum, urine, tissues and saliva[57,59]
Based on those findings four MiRNAs were identified as candidates for the detection of DON toxicity in porcine serum[58]


It seems that the use of biomarkers involved in critical signalling pathways and connected to the mode of action of mycotoxins may help predict their potential toxicity and the progression of associated mycotoxicosis, as well as to develop effective biomonitoring approaches[60]
Previous studies in pigs have provided evidence of multiple biomarkers of exposure to mycotoxins which correlate with the mycotoxins ingestion levels received:
The total DON concentration in serum and the sum of ZEN and metabolites in urine both have correlated well with the intake of the toxins from the feed[61]
DON concentration in serum and DON and DOM1 concentrations in urine increase in a dose-response-related manner as dietary DONconcentration increases[52]. Therefore, they are suitable biomarkers of exposure in pigs, whereas DON-GlcA in serum could be considered as a better biomarker for exposure[14]
DON-glucuronide (DON-GlcA) and ZENglucuronide (ZEN-GlcA) in plasma, DON and ZEN-GlcA in urine and, ZEN in faeces (late excretion due to enterohepatic circulation of ZEN) have been reported as optimal biomarkers for DON and ZEN[54]. According to the review by Tkaczyk, and Jedziniak[14], ZEN and its metabolites α- and β-ZEL in urine, as well as ZEN and its metabolites: α-, β-ZEL, and ZAN in faeces, or the plasma levels of GlcA metabolites (phase II metabolites) of ZEN, α-ZEL, and β-ZEL can also be suitable biomarkers of exposure in pigs.
Both plasma and urine FB1 levels are considered as adequate biomarkers of early exposure to low dietary levels and plasma is recommended under conditions of prolonged exposure (>14 days) in pigs. A correlation between FB1 in feed and hair has been also reported but was lower compared to urine and plasma[62]
The disruption of the sphingolipid biosynthesis can also be used as a biomarker for FB1 exposure, though it can be considered also as a biomarker of effect. The ratio Sa/So will increase in serum and tissues in a dose-dependent manner[63,64]
Measurement of AFB1-lysine concentration in serum demonstrated that longer exposure to AFB1 results in higher levels of AFB1-lysine, thus that the lysine adduct might be a good biomarker for long term AFB1 exposure[65]. In addition, AFB1-N7- guanine and AFM1 in urine have been also suggested as possible biomarkers for AFB1 exposure in pigs[15]. Tkaczyk et al.[14] identified AFB1, AFM1, and AFB2 as biomarkers of AFB1 exposure in the urine of pigs.
The concentrations of OTA in blood and urine have been reported as good markers for OTA contamination in various organs[15]
Several issues should be further clarified through research on the field of mycotoxicosis such as the occurrence and fate of modified or masked mycotoxins, as well as the interactions among mycotoxins when present as mycotoxin mixtures in contaminated pig feed.
The use of biomonitoring and the assessment of respective biomarkers seems a promising tool in understanding such complex procedures and their effects on health and performance of swine.
Early diagnosis of mycotoxicosis under field conditions based on biomarkers assessment in biological matrices should be well connected with respective feed contamination levels in order to lead to proper and timely performed counteracting measures regarding contaminated feed and the animals.
It should be stated that accurate – sensitive methods (at reasonable cost) of quick biomonitoring testing in biological matrices, received with minimal animal restraint should be the focus of the future research efforts on the field of mycotoxicosis diagnostics and especially in cases of combined mycotoxicosis exposure.
Nevertheless, taking into account the complexity of sampling preparation for such analysis and the concurrent presence of multiple mycotoxins with different toxicokinetic properties, it seems that the preparation of such technology would not be an easy task.

1) Santos Pereira, C.; Cunha, S.C.; Fernandes, J.O. Prevalent Mycotoxins in Animal Feed: Occurrence and Analytical Methods. Toxins 2019, 11, 290.
2) Döll, S.; Dänicke, S. The Fusarium toxins deoxynivalenol (DON) and zearalenone (ZEN) in animal feeding. Prev. Vet. Med. 2011, 102, 132–145.
3) Streit E, Schatzmayr G, Tassis P, Tzika E, Marin D, Taranu I, Tabuc C, Nicolau A, Aprodu I, Puel O, Oswald IP. Current situation of mycotoxin contamination and co-occurrence in animal feed--focus on Europe. Toxins (Basel). 2012 Oct;4(10):788-809. doi: 10.3390/toxins4100788.
4) Ricciardi C., Castagna R., Ferrante I., Frascella F., Marasso S.L., Ricci A., Canavese G., Lorè A., Prelle A., Gullino M.L., et al. Development of a microcantilever-based immunosensing method for mycotoxin detection. Biosens. Bioelectron. 2013;40:233–239. doi: 10.1016/j.bios.2012.07.029.
5) Eskola M., Kos G., Elliott C.T., Hajslova J., Mayar S., Krska R. Worldwide contamination of food-crops with mycotoxins: Validity of the widely cited ‘FAO estimate’ of 25% Crit. Rev. Food Sci. Nutr. 2020;60:2773–2789. doi: 10.1080/10408398.2019.1658570.
6) Gruber-Dorninger, C.; Jenkins, T.; Schatzmayr, G. Global Mycotoxin Occurrence in Feed: A Ten-Year Survey. Toxins 2019, 11, 375. https://doi. org/10.3390/toxins11070375.
7) European Commission Directive 2002/32/EC of The European Parliament and of The Council of 7 May 2002 on Undesirable Substances in Animal Feed. Off. J. Eur. Union. 2019;L289:32–36.
8) European Commission Commission Recommendation of 17 August 2006 on the Presence of Deoxynivalenol, Zearalenone, Ochratoxin A, T-2 and HT-2 and Fumonisins in Products Intended for Animal Feeding. Off. J. Eur. Union. 2006;49:7–9.
9) Strimbu K, Tavel JA. What are biomarkers? Curr Opin HIV AIDS. 2010 Nov;5(6):463-6. doi: 10.1097/COH.0b013e32833ed177.
10) Biomarkers Definition Working Group Biomarkers and surrogate endpoints: preferred definitions and conceptual framework. Clin Pharmacol Therapeutics. 2001;69:89–95.
11) Alvito, P.; Assun.ão, R.M.; Bajard, L.; Martins, C.; Mengelers, M.J.B.; Mol, H.; Namorado, S.; van den Brand, A.D.; Vasco, E.; Viegas, S.; et al. Current Advances, Research Needs and Gaps in Mycotoxins Biomonitoring under the HBM4EU—Lessons Learned and Future Trends. Toxins 2022, 14, 826.
12) Viegas, S.; Assun.ão, R.; Martins, C.; Nunes, C.; Osteresch, B.; Twaru˙ zek, M.; Kosicki, R.; Grajewski, J.; Ribeiro, E.; Viegas, C. Occupational Exposure to Mycotoxins in Swine Production: Environmental and Biological Monitoring Approaches. Toxins 2019, 11, 78.
13) Arce-López, B.; Lizarraga, E.; Vettorazzi, A.; González-Pe.as, E. Human Biomonitoring of Mycotoxins in Blood, Plasma and Serum in Recent Years: A Review. Toxins 2020, 12, 147.
14) Tkaczyk, A.; Jedziniak, P. Mycotoxin Biomarkers in Pigs—Current State of Knowledge and Analytics. Toxins 2021, 13, 586.
15) Lauwers M. (2019). Biomarkers for mycotoxin exposure in livestock. PhD study. Ghent University.
16) Sherif, S.O.; Salama, E.E.; Abdel-Wahhab, M.A. Mycotoxins and child health: The need for health risk assessment. Int. J. Hyg. Environ. Health 2009, 212, 347–368, doi:10.1016/j.ijheh.2008.08.002.
17) Dersjant-Li Y, Verstegen MW a, Gerrits WJJ. The impact of low concentrations of aflatoxin, deoxynivalenol or fumonisin in diets on growing pigs and poultry. Nutr Res Rev 2003;16:223–39. doi:10.1079/NRR200368.
18) Thieu NQ, Pettersson H. Zearalenone, deoxynivalenol and aflatoxin B1 and their metabolites in pig urine as biomarkers for mycotoxin exposure. Mycotoxin Res. 2009 Jun;25(2):59-66. doi: 10.1007/s12550-009-0009-z.
19) Luthy, J.; Zweifel, U.; Schlatter, C. Metabolism [ 14C ] Aflatoxin B , in Pigs. Food Cosmet. Toxicol. Cosmet toxicol 1980, 18, 253–256.
20) Turner PC, Snyder JA. Development and Limitations of Exposure Biomarkers to Dietary Contaminants Mycotoxins. Toxins (Basel). 2021 Apr 28;13(5):314. doi: 10.3390/toxins13050314.
21) Guengerich F.P., Ueng Y.-F., Kim B.-R., Langouet S., Coles B., Iyer R.S., Thier R., Harris T.M., Shimada T., Yamazaki H., et al. Activation of Toxic Chemicals by Cytochrome P450 Enzymes: Regio- and Stereoselective Oxidation of Aflatoxin B1. In: Snyder R., Sipes I.G., Jollow D.J., Monks T.J., Kocsis J.J., Kalf G.F., Greim H., Witmer C.M., editors. Biological Reactive Intermediates V. Volume 387. Springer; Boston, MA, USA: 1996. pp. 7–15. Advances in Experimental Medicine and Biology.
22) Essigmann J.M., Croy R.G., Nadzan A.M., Busby W.F., Reinhold V.N., Büchi G., Wogan G.N. Structural Identification of the Major DNA Adduct Formed by Aflatoxin B1 in Vitro. Proc. Natl. Acad. Sci. USA. 1977;74:1870–1874. doi: 10.1073/pnas.74.5.1870.
23) Raney V.M., Harris T.M., Stone M.P. DNA Conformation Mediates Aflatoxin B1-DNA Binding and the Formation of Guanine N7 Adducts by Aflatoxin B1 8,9-Exo-Epoxide. Chem. Res. Toxicol. 1993;6:64–68. doi: 10.1021/tx00031a010.
24) Forsyth DM, Yoshizawa T, Morooka N, Tuite J. Emetic and refusal activity of deoxynivalenol to swine. Appl Environ Microbiol. 1977 Nov;34(5):547-52. doi: 10.1128/aem.34.5.547-552.1977.
25) Pestka JJ. Deoxynivalenol: mechanisms of action, human exposure, and toxicological relevance. Arch Toxicol. 2010 Sep;84(9):663-79. doi: 10.1007/s00204-010-0579-8.
26) Ghareeb K, Awad WA, Böhm J, Zebeli Q. Impacts of the feed contaminant deoxynivalenol on the intestine of monogastric animals: poultry and swine. J Appl Toxicol. 2015 Apr;35(4):327-37. doi: 10.1002/jat.3083.
27) Dänicke S, Goyarts T, Valenta H. On the specific and unspecific effects of a polymeric glucomannan mycotoxin adsorbent on piglets when fed with uncontaminated or with Fusarium toxins contaminated diets. Arch Anim Nutr. 2007 Aug;61(4):266-75. doi: 10.1080/17450390701431854.
28) Dänicke, S.; Brezina, U. Kinetics and metabolism of the Fusarium toxin deoxynivalenol in farm animals: Consequences for diagnosis of exposure and intoxication and carry over. Food Chem. Toxicol. 2013, 60, 58–75.
29) Eriksen, G.S.; Pettersson, H.; Johnsen, K.; Lindberg, J.E. Transformation of trichothecenes in ileal digesta and faeces from pigs.Arch. Anim. Nutr. 2002, 56, 263–274.
30) Broekaert N, Devreese M, van Bergen T, Schauvliege S, De Boevre M, De Saeger S, Vanhaecke L, Berthiller F, Michlmayr H, Malachová A, Adam G, Vermeulen A, Croubels S. In vivo contribution of deoxynivalenol-3-β-D-glucoside to deoxynivalenol exposure in broiler chickens and pigs: oral bioavailability, hydrolysis and toxicokinetics. Arch Toxicol. 2017 Feb;91(2):699-712. doi: 10.1007/s00204-016-1710-2.
31) Meky F.A., Turner P.C., Ashcroft A.E., Miller J.D., Qiao Y.L., Roth M.J., Wild C.P. Development of a Urinary Biomarker of Human Exposure to Deoxynivalenol. Food Chem. Toxicol. 2003;41:265–273. doi: 10.1016/S0278-6915(02)00228-4.
32) Prelusky DB, Hartin KE, Trenholm HL, Miller JD. Pharmacokinetic fate of 14C-labeled deoxynivalenol in swine. Fundam Appl Toxicol. 1988 Feb;10(2):276-86. doi: 10.1016/0272-0590(88)90312-0.
33) Eriksen GS, Pettersson H, Lindberg JE. Absorption, metabolism and excretion of 3-acetyl DON in pigs. Arch Tierernahr. 2003 Oct;57(5):33545. doi: 10.1080/00039420310001607699.
34) Dänicke S, Goyarts T, Valenta H, Razzazi E, Böhm J. On the effects of deoxynivalenol (DON) in pig feed on growth performance, nutrients utilization and DON metabolism. Journal of Animal and Feed Sciences. 2004;13(4):539-556. doi:10.22358/jafs/67624/2004.
35) Dänicke S., Valenta H., Döll S., Ganter M., Flachowsky G. On the effectiveness of a detoxifying agent in preventing fusario-toxicosis in fattening pigs. Anim. Feed Sci. Technol. 2004;114:141–157. doi: 10.1016/j.anifeedsci.2003.11.012.
36) Dänicke S, Valenta H, Klobasa F, Döll S, Ganter M, Flachowsky G. Effects of graded levels of Fusarium toxin contaminated wheat in diets for fattening pigs on growth performance, nutrient digestibility, deoxynivalenol balance and clinical serum characteristics. Arch Anim Nutr. 2004 Feb;58(1):1-17. doi: 10.1080/0003942031000161045.
37) Goyarts T, Dänicke S. Bioavailability of the Fusarium toxin deoxynivalenol (DON) from naturally contaminated wheat for the pig. Toxicol Lett. 2006 Jun 1;163(3):171-82. doi: 10.1016/j.toxlet.2005.10.007.
38) Pitt J.I., Miller J.D. A Concise History of Mycotoxin Research. J. Agric. Food Chem. 2017;65:7021–7033. doi: 10.1021/acs.jafc.6b04494.
39) Schertz H, Kluess J, Frahm J, Schatzmayr D, Dohnal I, Bichl G, Schwartz-Zimmermann H, Breves G, Dänicke S. Oral and Intravenous Fumonisin Exposure in Pigs-A Single-Dose Treatment Experiment Evaluating Toxicokinetics and Detoxification. Toxins (Basel). 2018 Apr 5;10(4):150. doi: 10.3390/toxins10040150.
40) Fodor J, Balogh K, Weber M, Miklós M, Kametler L, Pósa R, Mamet R, Bauer J, Horn P, Kovács F, Kovács M. Absorption, distribution and elimination of fumonisin B(1) metabolites in weaned piglets. Food Addit Contam Part A Chem Anal Control Expo Risk Assess. 2008 Jan;25(1):8896. doi: 10.1080/02652030701546180.
41) Pierron A., Alassane-Kpembi I., Oswald I.P. Impact of two mycotoxins deoxynivalenol and fumonisin on pig intestinal health. Porc. Heal. Manag. 2016;2:1–8. doi: 10.1186/s40813-016-0041-2.
42) Haschek WM, Gumprecht LA, Smith G, Tumbleson ME, Constable PD. Fumonisin toxicosis in swine: an overview of porcine pulmonary edema and current perspectives. Environ Health Perspect. 2001 May;109 Suppl 2(Suppl 2):251-7. doi: 10.1289/ehp.01109s2251.
43) Ringot D, Chango A, Schneider YJ, Larondelle Y. Toxicokinetics and toxicodynamics of ochratoxin A, an update. Chem Biol Interact. 2006 Jan 5;159(1):18-46. doi: 10.1016/j.cbi.2005.10.106.
44) Kőszegi T, Poór M. Ochratoxin A: Molecular Interactions, Mechanisms of Toxicity and Prevention at the Molecular Level. Toxins (Basel). 2016 Apr 15;8(4):111. doi: 10.3390/toxins8040111.
45) Hagelberg S., Hult K., Fuchs R. Toxicokinetics of Ochratoxin A in Several Species and Its Plasma-Binding Properties. J. Appl. Toxicol. 1989;9:91–96. doi: 10.1002/jat.2550090204.
46) Wu Q, Dohnal V, Huang L, Kuča K, Wang X, Chen G, Yuan Z. Metabolic pathways of ochratoxin A. Curr Drug Metab. 2011 Jan;12(1):1-10. doi: 10.2174/138920011794520026.
47) Ringot D, Chango A, Schneider YJ, Larondelle Y. Toxicokinetics and toxicodynamics of ochratoxin A, an update. Chem Biol Interact. 2006 Jan 5;159(1):18-46. doi: 10.1016/j.cbi.2005.10.106.
48) Dänicke S, Winkler J. Invited review: Diagnosis of zearalenone (ZEN) exposure of farm animals and transfer of its residues into edible tissues (carry over). Food Chem Toxicol. 2015 Oct;84:225-49. doi: 10.1016/j.fct.2015.08.009.
49) Bielas W, Niżański W, Nicpoń J, Nicpoń JE, Partyka A, Mordak R, Nowak M, Ciaputa R. Effect of zearalenone on circulating testosterone concentration, testicular and epididymal morphology and epididymal sperm characteristics in wild boars. Theriogenology. 2017 Oct 15;102:59-66. doi: 10.1016/j.theriogenology.2017.07.015.
50) Olsen M, Malmlof K, Pettersson H, Sandholm K, Kiessling KH (1985b) Plasma and urinary levels of zearalenone and alphazearalenol in a prepubertal gilt fed zearalenone. Acta Pharmacol Toxicol (Copenh) 56:239–243.
51) Zöllner P, Jodlbauer J, Kleinova M, Kahlbacher H, Kuhn T, Hochsteiner W, Lindner W. Concentration levels of zearalenone and its metabolites in urine, muscle tissue, and liver samples of pigs fed with mycotoxin-contaminated oats. J Agric Food Chem. 2002 Apr 24;50(9):2494-501. doi: 10.1021/jf0113631.
52) Dänicke S, Brüssow KP, Valenta H, Ueberschär KH, Tiemann U, Schollenberger M. On the effects of graded levels of Fusarium toxin contaminated wheat in diets for gilts on feed intake, growth performance and metabolism of deoxynivalenol and zearalenone. Mol Nutr Food Res. 2005 Oct;49(10):932-43. doi: 10.1002/mnfr.200500050.
53) Oyejide, L.; Mendes, O.R.; Mikaelin, I. Chapter 16-Molecular pathology: applications in nonclinical drug development. A Compr. Guid. to Toxicol. nonclinical drug Dev. (second Ed. 2017, 407–445.
54) Lauwers, M.; Croubels, S.; Letor, B.; Gougoulias, C.; Devreese, M. Biomarkers for Exposure as A Tool for Efficacy Testing of A Mycotoxin Detoxifier in Broiler Chickens and Pigs. Toxins. 2019, 11, 187
55) EFSA FEEDAP Panel (EFSA Panel on additives and products or substances used in animal feed) 2018. Guidance on the assessment of the efficacy of feed additives. EFSA Journal 2018;16 (5):5274, 25 pp. https://doi.org/10.2903/j.efsa.2018.5274.
56) Lauwers M, Croubels S, De Baere S, Sevastiyanova M, Romera Sierra EM, Letor B, Gougoulias C, Devreese M. Assessment of Dried Blood Spots for Multi-Mycotoxin Biomarker Analysis in Pigs and Broiler Chickens. Toxins (Basel). 2019 Sep 18;11(9):541. doi: 10.3390/toxins11090541.
57) Grenier, B., Hackl, M., Skalicky, S. et al. MicroRNAs in porcine uterus and serum are affected by zearalenone and represent a new target for mycotoxin biomarker discovery. Sci Rep 9, 9408 (2019). https://doi.org/10.1038/s41598-019-45784-x
58) Segura-Wang M, Grenier B, Ilic S, Ruczizka U, Dippel M, Bünger M, Hackl M, Nagl V. MicroRNA Expression Profiling in Porcine Liver, Jejunum and Serum upon Dietary DON Exposure Reveals Candidate Toxicity Biomarkers. Int J Mol Sci. 2021 Nov 7;22(21):12043. doi: 10.3390/ ijms222112043.
59) Chen J, Yang S, Li P, Wu A, Nepovimova E, Long M, Wu W, Kuca K. MicroRNA regulates the toxicological mechanism of four mycotoxins in vivo and in vitro. J Anim Sci Biotechnol. 2022 Feb 24;13(1):37. doi: 10.1186/s40104-021-00653-4.
60) Vidal, A.; Mengelers, M.; Yang, S.; De Saeger, S.; De Boevre, M. Mycotoxin Biomarkers of Exposure: A Comprehensive Review. Compr. Rev. Food Sci. Food Saf. 2018, 17, 1127–1155, doi:10.1111/1541-4337.12367.
61) Brezina, U.; Rempe, I.; Kersten, S.; Valenta, H.; Humpf, H.U.; Dänicke, S. Diagnosis of intoxications of piglets fed with Fusarium toxin-contaminated maize by the analysis of mycotoxin residues in serum, liquor and urine with LC-MS/MS. Arch. Anim. Nutr. 2014, 68, 425–447, doi:10.108 0/1745039X.2014.973227.
62) Souto, P.C.M.C.; Jager, A. V.; Tonin, F.G.; Petta, T.; Di Gregório, M.C.; Cossalter, A.M.; Pinton, P.; Oswald, I.P.; Rottinghaus, G.E.; Oliveira, C.A.F. Determination of fumonisin B1levels in body fluids and hair from piglets fed fumonisin B1-contaminated diets. Food Chem. Toxicol. 2017, 108, 1–9, doi:10.1016/j.fct.2017.07.036.
63) Shephard, G.S.; van der Westhuizen, L.; Sewram, V. Biomarkers of exposure to fumonisin mycotoxins: A review. Food Addit. Contam. 2007, 24, 1196–1201, doi:10.1080/02652030701513818.
64) Riley, R.T.; An, N.H.; Showker, J.L.; Yoo, H.S.; Norred, W.P.; Chamberlain, W.J.; Wang, E.; Merrill, A.H.; Motelin, G.; Beasley, V.R.; et al. Alteration of tissue and serum sphinganine to sphingosine ratio: An early biomarker of exposure to fumonisin-containing feeds in pigs. Toxicol. Appl. Pharmacol. 1993, 118, 105–112.
65) Di Gregorio, M.C.; Jager, A. V.; Costa, A.A.; Bordin, K.; Rottinhghaus, G.E.; Petta, T.; Souto, P.C.M.C.; Budiño, F.E.L.; Oliveira, C.A.F.
Determination of Aflatoxin B 1 -Lysine in Pig Serum and Plasma by Liquid Chromatography–Tandem Mass Spectrometry. J. Anal. Toxicol. 2016, 41, 236–241, doi:10.1093/jat/bkw126.